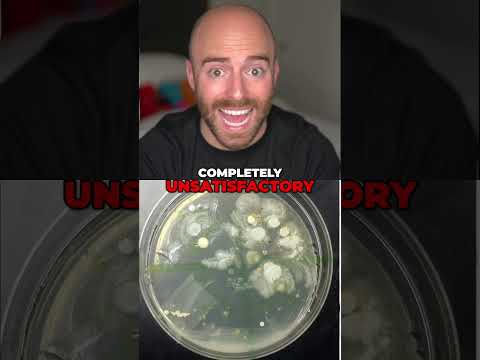
Your Kitchen Faucet: Germier Than Your Toilet

Matthew Santoro YouTube Videos Stats

27 Hands Found! Russian K!*ler or Forensics?

Vaseline Creator's Daily Habit & Russian Wolf Pack Mystery

Star Trek, Star Wars & Edison: Amazing Hollywood Stories

Jurassic Park Secret Sound Revealed! Weird Festival Facts

Disney's Explosives Secret & Giant Snowflakes!

Video Games Heal Trauma: Tetris Prevents Bad Memories!

Master Abdominal Breathing: Reduce Stress & Anxiety Now!

Laugh Your Way to Better Memory & Mood!

Inversion Therapy: Boost Brain Function & Memory Instantly

Backyard Discovery: WWII Grenades Found in Czech Republic

Pele's Hair: The Golden Lava Strands You Won't Believe Exist!

Mystery of Ocean Sand Circles: How Tiny Fish Create Giant Art!

Eye of Sahara: The Mysterious Crater You Won't Believe Exists!

Blood Falls: The Vampire Waterfall in Antarctica!

Million Dollar Coin Find: Nevada Gold Rush Treasure!

Hidden Ferrari: The Incredible Dino Find in LA!

Austria's Medieval Treasure: Accidental Backyard Discovery!

Yuk the Dog: The Hideous Hero's Secret Weapon!

Superdupont: Satire of French Stereotypes in Comics

Danny the Street: The Living Superhero's Crazy Powers!

Big Bertha's Silly Transformation: Milwaukee Model's Secret!

World's First Insult: Ancient Babylon's Mother Joke

GPS: How We Navigated Before Satellites

Ancient Genius: The First Automatic Door 2000 Years Ago!

Ancient Egyptians Wore Hair Extensions 3300 Years Ago!

Unbelievable Facts: Baldur's Gate III, Jaco, and More!

Amazing Facts: Saturn Floats, Bra Origins, And More!

Amazing Facts: Octopus Camouflage, Popcorn Lung, & Coffee History

50 Mind Blowing Facts: Shrews, Hurricanes & Bonobos!

William Knudsen & Steven Doren: American Industrial Titans

Sauna Benefits & Johnny Cash: Surprising Health Secrets!

Kris Kristofferson Lands Helicopter on Johnny Cash's Lawn!

Elvis's Twin, Jay Z Ban, and Dark Souls Creator Ban!

Sweden's Sunken Skulls: Unearthing a Bizarre Archeological Find

Rosetta Stone: Unlocking Ancient Egyptian Secrets!

Headless Vikings: Uncovering Dorset's Shocking Mass Grave

Dinosaur Claw Discovery: Ancient Moa Found in New Zealand

Why Do We Yawn? Science Reveals the Truth!

Why Bicycles Work: The Physics Mystery Explained!

Time Doesn't Exist: Mind Blowing Physics Explained!

Are Plants Intelligent? Shocking Facts About Plants

Pandemics: History's Deadly Flu & Why We're So Vulnerable

Is The Sun Going To KILL Us?! Solar Flares Explained!

Doomsday Clock: Is the End of the World Near Find Out!

AI Apocalypse: Stephen Hawking & Elon Musk Warn Us!

Skull and Bones: The Secret Yale Society's Power Revealed

Knights Templar: History, Secrets, and Economic Influence

Illuminati: Unveiling the Truth Behind the Secret Society

Freemasons: The Secret Society's Influence EXPOSED!

Worst Theoretical Prediction to Train Crash! 🤯 History's Darkest Truths

US History Facts: Mine Wars & Lincoln's Penny!

Unbelievable Facts: Poodles, Mysterious Deaths, and Stubborn Prisoners!

Simpsons Spinoff Shelved! Crazy Finance Jobs! Lemonade Legal Aid !

Sweden's Open Data: Address, Age, and Privacy Explained

Banned Hugs & Burger King: Crazy Celebrity Perks!

Amazing Facts: Pangolins, Bhutan, and Maned Wolves!

Amazing Facts: Hurricane, Fatty Liver, & Millionaire!

Serial K!ller Edmund Kemper: Gru*some Crimes & Chilling Confession

Nikolas Cruz: Voices Drove Him To Burn, K!ll, Destroy Everything

Mom P0isons Family With Antifreeze, Daughter Confesses!

Man K!LLS Mom, LAUGHS, Tries to BURN Brother AL!VE!

CRAZY DEMOGORGON BUG! http://twitch.tv/matthewsantoro LIVE NOW playing #deadbydaylight #dbd

Woman Fakes Pregnancy & Attacks Pregnant Mom: The Shocking True Story

Pulse Nightclub: Remembering the Tr*gedy and Omar Mateen's Attack

Ohio 911 Call: Woman's Escape Leads to Shocking Discovery!

911: The Untold Story of Kevin Cosgrove's F!nal Moments

Kobe into Hatch! http://twitch.tv/matthewsantoro LIVE NOW playing #deadbydaylight #dbd

Tapeworm Diet: The D*ngerous Weight Loss Fad You NEED To Know!

Psychedelic Mushrooms: Ancient Medicine to Modern Mystery

LSD Therapy: The Forgotten Medicine for Mental Health

Pallet fun in 2v8 😂 #deadbydaylight #dbd

Chocolate: From Ancient Miracle Cure to Candy Bowl

Paris Catacombs EXPLORER Vanishes in Creepy Recorded Footage!

Mysterious Cave Vibrations Led To Disappearance !

KOBE Into HATCH Against GHOUL! #deadbydaylight #dbd

Florida Man Pulled Underground By Mysterious Sinkhole!

Cave Explorer Vanishes Leaving ONLY Clothes Behind

WWII Spy & Hollywood Secrets: You Won't Believe These Facts!

ULTIMATE SKILL CHECK TEST http://twitch.tv/matthewsantoro LIVE NOW playing #deadbydaylight #dbd
 0:00
0:00
Your Cutting Board is 200X Dirtier Than Your Toilet!
0:00
0:00
Your Kitchen Faucet: Germier Than Your Toilet
 0:00
0:00
Your Keyboard is 20,000x Dirtier Than Your Toilet!
 0:00
0:00
I'm Still Alive... (Live daily on Twitch! https://twitch.tv/matthewsantoro)
 0:00
0:00
Dog Water Bowls: Deadly Bacteria Lurking In Your Pet's Dish!
 0:00
0:00
I'm Still Alive...
 0:00
0:00
Surgeon Simulator Glitch: Blood Tears, Head Explosion!
 0:00
0:00
Rocky PS2: The Most Terrifying Boxing Game Glitches!
 0:00
0:00
Crisis Land Sharks: The Most Terrifying Gaming Bug EVER!
 0:00
0:00
Bizarre Video Game Glitches: Mafia II Demons!
 0:00
0:00
Toilet Restaurant in Taiwan: A Crappy or Brilliant Idea?
 0:00
0:00
Restaurant Built on a Cemetery: Bizarre Eating!
 0:00
0:00
Eating in the Dark: Toronto Restaurant's Unique Experience
 0:00
0:00
50 AMAZING Facts to Blow Your Mind! 299
 0:00
0:00
Cabbages and C0ndoms: The Restaurant Promoting Safe S*x!
 0:00
0:00
Photographer Captures Eerie Ghost Child in Wedding Shoot!
 0:00
0:00
Ghost photo STUNS investigators in abandoned cemetery!
 0:00
0:00
Ghost Photo CLAIMS To Show Vengeful Spirit GRABBING A Woman!
 0:00
0:00
Ghost Hand Caught on Photo! Former Owner's Spirit: Unexplained Mystery!
 0:00
0:00
Mysterious Illness Strikes US Diplomats: What's Behind It